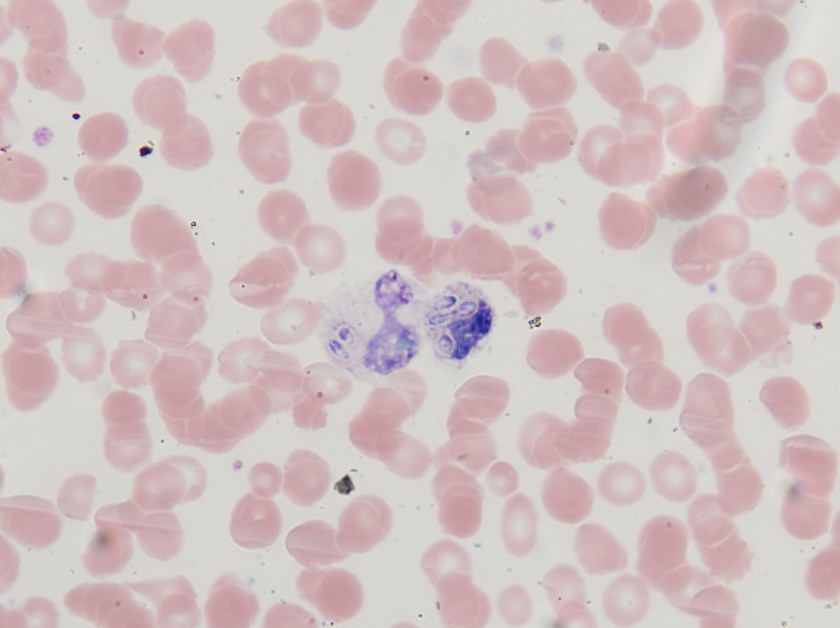
histo1
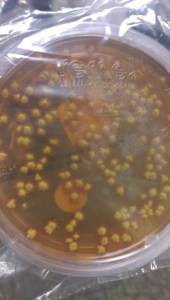
Colony morphology on fungal media.
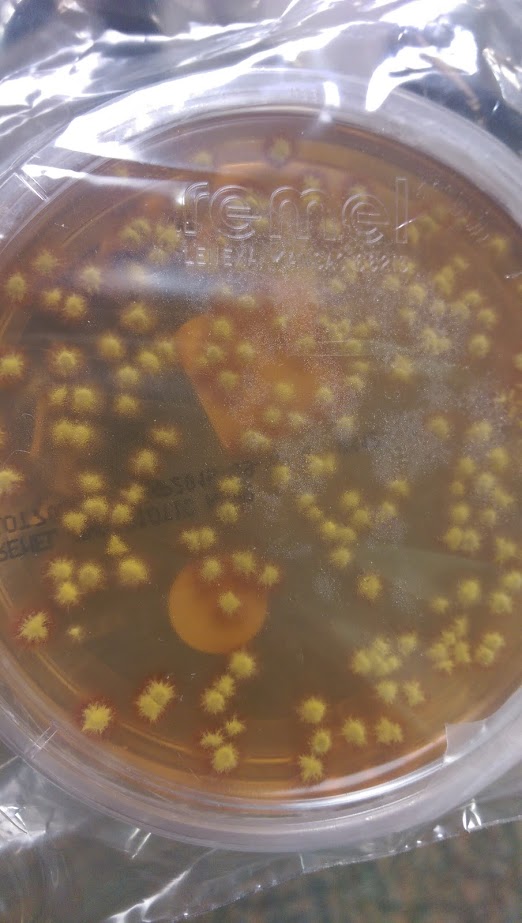

Case History
A 61 year old African American male presents to the emergency department with complaints of a productive cough, dyspnea and altered mental status. His past medical history is significant for HIV and currently he is non-compliant with his anti-retroviral medications. On arrival, he is found to be hypoglycemic (glucose 49 mg/dL) and tachycardic (heart rate between 160-180 beats/min). He lives in a group home and they report decreased oral intake for several days but he denies fever, chills, chest pain or abdominal pain. He is a tobacco smoker and admits to previous illicit drug use. On physical exam, he is lethargic and respiratory auscultation reveals coarse lung sounds, bilaterally. A chest x-ray shows bilateral interstitial and airspace opacities suggestive of an infectious process. His CD4 count is markedly decreased at 3 cells/cmm. Peripheral blood and bronchoalveolar lavage (BAL) fluid are sent to the hematology and cytology laboratories for microscopic examination. Blood and BAL specimens were also transported to the microbiology lab for bacterial, fungal and mycobacterial cultures.
Laboratory Identification

Both the peripheral blood smear and BAL showed intracellular, small, ovoid yeast cells with narrow based budding (Figures 1 & 2). The yeast forms measured between 2-4 µm in diameter. The characteristic “acorn-like” appearance of the yeast cells surrounded by a thin halo is the result of staining fixation. The blood and the BAL cultures grew white colonies with a fine, cottony texture after incubation for 21 days at 25°C (Figure 3). The mold form grew on Sabouraud dextrose, SAB with chloramphenicol and Mycosel agars. Microscopic morphology of a lactophenol cotton blue prep illustrated septate hyphae bearing round to pear-shaped microconidia as well as tuberculate, thick-walled macroconidia, which measured between 8-15 µm in size (Figure 4). The dimorphic mold was confirmed to be Histoplasma capsulatum by DNA probe testing. The patient also had a positive Histoplasma urinary antigen and fungitell was found to be >500 pg/ml.
Discussion
Histoplasma capsulatum is a thermally dimorphic fungus and the most common endemic mycosis in North America. In the United States, the disease is most prevalent in areas surrounding the Mississippi and Ohio River valleys. Inhalation of conidia occurs as a result of environmental exposure to soil contaminated with bird dropping or exploring caves and other dwelling inhabited by bats. Pulmonary infections are the most frequent manifestation of disease; however, disseminated infection can occur in individuals with underlying cell-mediated immunological defects, including those with HIV, transplant recipients, and individuals receiving tumor necrosis factor alpha inhibitors for rheumatologic conditions. Other extra-pulmonary sites from which H. capsulatum has been isolated include the skin, liver, spleen, central nervous system and bone marrow.
In the environment and when cultured in the laboratory at 25°C, H. capsulatum is a filamentous mold and exhibits both pear shaped microconidia (2-5 µm) and thick walled macroconidia that display characteristic tubercles or projections on their surface (8-15 µm). The yeast phase occurs in tissue and at temperatures above 35°C. The yeast phase is characterized as small oval budding cells, 2-4 µm in diameter and are often found in clusters within macrophages. Historically, mold to yeast culture conversion was used to confirm the diagnosis, but with the advent of more rapid DNA probe technologies, this has been discontinued. Other rapid tests routinely utilized include a urine test to detect the Histoplasma antigen.
H. capsulatum var. duboisii, which is endemic in central and western Africa, is also implicated in causing disease in humans. It can be distinguished from H. capsulatum var. capsulatum due to its larger diameter in tissue where the yeast form of H. capsulatum var. duboisii measures between 8-15 µm in diameter as opposed to 2-4 µm for var. capsulatum. Caution is recommended, however, due to the yeast forms of the two variants being the same size when grown in culture.
Amphotericin B is the antifungal agent used to treat disseminated histoplasmosis infections. In cases of less severe disease, itraconazole is effective and commonly utilized. In the case of our patient, he received 14 days of amphotericin B infusion as an inpatient and was then transitioned to oral itraconazole upon discharge.

-Joy King, MD, is a third year Anatomic and Clinical Pathology resident at the University of Mississippi Medical Center.

-Lisa Stempak, MD, is an Assistant Professor of Pathology at the University of Mississippi Medical Center in Jackson, MS. She is certified by the American Board of Pathology in Anatomic and Clinical Pathology as well as Medical Microbiology. Currently, she oversees testing performed in both the Chemistry and Microbiology Laboratories. Her interests include infectious disease histology, process and quality improvement and resident education.